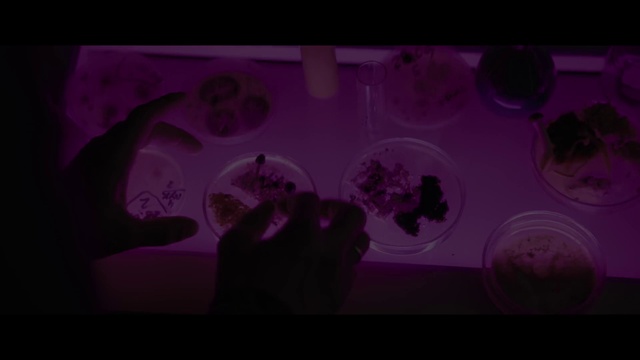
Thumbnail

Images and videos may be copyrighted. Refsee is a search engine that scans the internet and provides the searcher with any relevant results.
AI-Generated image
You can use this image for commercial purposes. This image was generated using a neural network and is therefore not copyrighted.